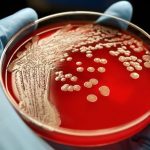
Rischio infettivo, il ruolo centrale dell’infermiere

In una lettera aperta il ministro della Salute ha toccato le tematiche di maggiore attualità riguardanti la professione.
Una giornata storica, quella della nascita dell’Ordine degli infermieri, ma ora “tocca a voi e alla vostra Federazione, insieme con il ministero, dare concretezza a questa trasformazione, che non deve essere intesa solo come un cambio di denominazione, ma come una modifica fondamentale dell’ordinamento della vostra professione, riconoscendola finalmente come professione intellettuale”.
Scrive così il ministero della Salute, Beatrice Lorenzin, in una lettera aperta inviata agli infermieri nel giorno dell’entrata in vigore della legge 3/2018, che porta il suo nome e che, dopo tanti anni di attesa, rende concreto l’obiettivo di trasformare i Collegi in Ordini professionali. Una giornata, questa, che Lorenzin definisce momento di partenza e non di arrivo “di un percorso che abbiamo cominciato insieme e che vi vedrà protagonisti del sistema sanitario italiano nei prossimi anni”.
“Questi cinque anni da ministro – si legge ancora nella lettera – mi hanno consentito di apprezzare le doti professionali e umane della vostra professione e di riconoscere l’infungibilità da parte del Sistema sanitario del vostro ruolo”. Lorenzin delinea poi obiettivi e tappe future. A cominciare dal contratto, perché “dopo dieci anni, si è riaperta la partita del rinnovo, che so complessa e difficile, anche per le giuste aspettative giuridiche ed economiche che si sono sedimentate in questa lunga attesa e per il cambiamento che la vostra professione ha vissuto in questo periodo, che porta con sé l’affrontare tematiche profonde quali quelle delle competenze specialistiche e dello sviluppo della carriera gestionale degli infermieri”.
Quindi un’area autonoma di contrattazione: “Mi è ben noto che rappresentate circa il 40% degli operatori che a vario titolo prestano la loro opera nel Servizio sanitario azionale, per cui ritengo giunto ormai il tempo di avviare una riflessione più ampia sul tema della creazione di un’area autonoma di contrattazione per la vostra professione, in maniera tale da riconoscere la peculiarità e particolarità del qualificato lavoro che ognuno di voi garantisce quotidianamente per la salute dei nostri cittadini”.
Il ministro si augura che le Regioni sblocchino i concorsi e avviino le stabilizzazioni del personale precario, “grazie al quale, in questi anni di blocco del turnover, è stato possibile garantire l’erogazione delle prestazioni”, ma rivolge una pensiero anche ad aggressioni e violenze “che riguardano sempre più frequentemente voi, prima interfaccia nelle strutture di pronto soccorso e in tutte le realtà che intercettano pazienti con bisogni complessi”.
Significativo, infine, questo passaggio: “Lo voglio dire con fermezza: bisogna ridare dignità a una professione che merita un ringraziamento grande da tutti noi per l’abnegazione e la professionalità che mette nel fornire giornalmente cure e attenzione ai soggetti più deboli della società”.
C’è molto da fare ancora, secondo Lorenzin. Soprattutto, conclude la lettera, per disegnare un “nuovo modello di assistenza infermieristica che dovrà essere coerente con la modifica dei bisogni di salute dei nostri cittadini, che chiedono sempre di più continuità delle cure, presa in carico e maggiore integrazione dei diversi operatori sanitari”.
Clicca QUI per leggere la lettera completa del ministro Lorenzin.
Fonte: www.ipasvi.it

Lascia un commento